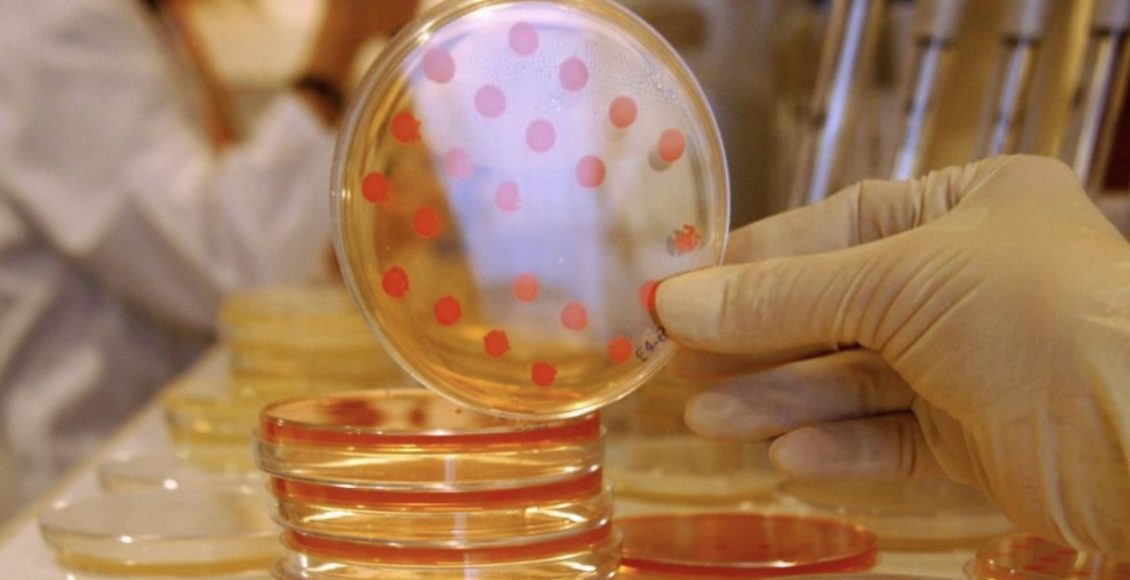

Imaginez une infection grave, une pneumonie ou même une septicémie. Jusqu’à récemment, un médecin aurait prescrit un antibiotique, et en quelques jours, vous auriez été sur pied. Mais aujourd’hui, il n’est plus garanti que le traitement fonctionne. La montée en flèche des bactéries résistantes aux antibiotiques, comme le Staphylococcus aureus résistant à la méthicilline (SARM), inquiète la communauté médicale mondiale. Selon l’Organisation mondiale de la santé (OMS), si rien n’est fait, des millions de vies pourraient être perdues, victimes de bactéries devenues insensibles aux traitements actuels.
Le danger est réel : certaines infections, autrefois bénignes, deviennent difficiles, voire impossibles, à traiter. En 2019, une étude révèle que 1,27 million de personnes ont perdu la vie à cause d’infections résistantes aux antibiotiques. La situation est particulièrement préoccupante pour les infections provoquées par les bactéries SARM, qui possèdent une résistance accrue grâce à un biofilm protecteur, une structure faite de protéines et de sucres qui agit comme une barrière contre les antibiotiques.
Une Découverte Scientifique : Comprendre et Déchiffrer le Biofilm Protecteur
Pour la première fois, des chercheurs de l’université d’Aarhus au Danemark, en collaboration avec l’Université de Pittsburgh, ont décrypté une partie de la structure moléculaire de ce biofilm protecteur. Cette avancée ouvre la voie à des traitements plus efficaces. Maria Andreasen, professeure associée au département de biomédecine de l’université d’Aarhus, et l’une des chercheuses à l’origine de cette étude, explique :
« Nous avons réussi à décrypter la structure moléculaire d’une partie cruciale de la bactérie S. aureus. Pour la première fois, nous comprenons comment certaines molécules spécifiques forment leur macrostructure. En étudiant cette organisation, nous espérons mettre au point de nouvelles stratégies pour empêcher la formation du biofilm, voire le décomposer. »
Ces travaux constituent une étape cruciale dans la lutte contre les infections résistantes, car en maîtrisant la formation de ce bouclier, les chercheurs pourraient faciliter le traitement de ces infections tenaces.
Le Staphylococcus aureus résistant à la méthicilline (SARM) : Qu’est-ce que c’est ?
Le SARM est une bactérie résistante à de nombreux antibiotiques courants, comme la méthicilline et la pénicilline. Cette résistance la rend particulièrement dangereuse dans les hôpitaux et les établissements de soins, où elle peut facilement infecter les personnes vulnérables, telles que les patients immunodéprimés ou ceux ayant des plaies ouvertes. Le SARM est capable de provoquer des infections graves, de la simple infection cutanée à la pneumonie ou même à la septicémie.
Voici quelques points clés sur le SARM :
• Bactérie commune: Staphylococcus aureus est une bactérie que beaucoup portent naturellement sur la peau ou dans le nez sans tomber malades. Mais une fois qu’elle pénètre dans le corps via une plaie, elle peut provoquer de graves infections.
• Résistance croissante: Le SARM est difficile à traiter car il résiste aux antibiotiques classiques. Les traitements nécessitent souvent des antibiotiques plus puissants, qui sont eux-mêmes limités dans leurs effets.
• Propagation en milieu hospitalier: En hôpital ou en maison de retraite, où les individus sont plus vulnérables, le SARM peut se propager rapidement et devenir difficile à contrôler.
• Risques pour la santé: Une infection à SARM peut rapidement devenir grave, voire fatale, surtout si elle se propage dans le sang ou atteint les organes vitaux.
Décrypter le Biofilm : Un Pas Vers des Traitements Plus Efficaces
Le biofilm, cette couche protectrice de protéines, rend la bactérie SARM extrêmement résistante aux traitements. Les travaux des chercheurs de l’Université d’Aarhus et de Pittsburgh ont permis de déchiffrer la structure de la protéine PSMα1, un amyloïde qui forme la base de ce biofilm. En comprenant comment ce bouclier se forme et en identifiant ses faiblesses, ils espèrent développer de nouvelles molécules capables d’empêcher la formation du biofilm ou de le dégrader, rendant ainsi les infections plus facilement traitables.
Une Menace Mondiale qui Nécessite une Réponse Urgente
Pour Maria Andreasen et son équipe, ces découvertes sont une avancée majeure. Cependant, la menace des bactéries résistantes reste un défi global et complexe qui nécessite un effort concerté des gouvernements, des scientifiques et des acteurs de la santé. Les recherches sur la résistance aux antibiotiques et sur le biofilm protecteur des bactéries SARM pourraient, dans les années à venir, permettre de sauver des millions de vies et de mieux protéger les populations contre cette menace silencieuse mais dévastatrice.
Nouhad Ourebzani